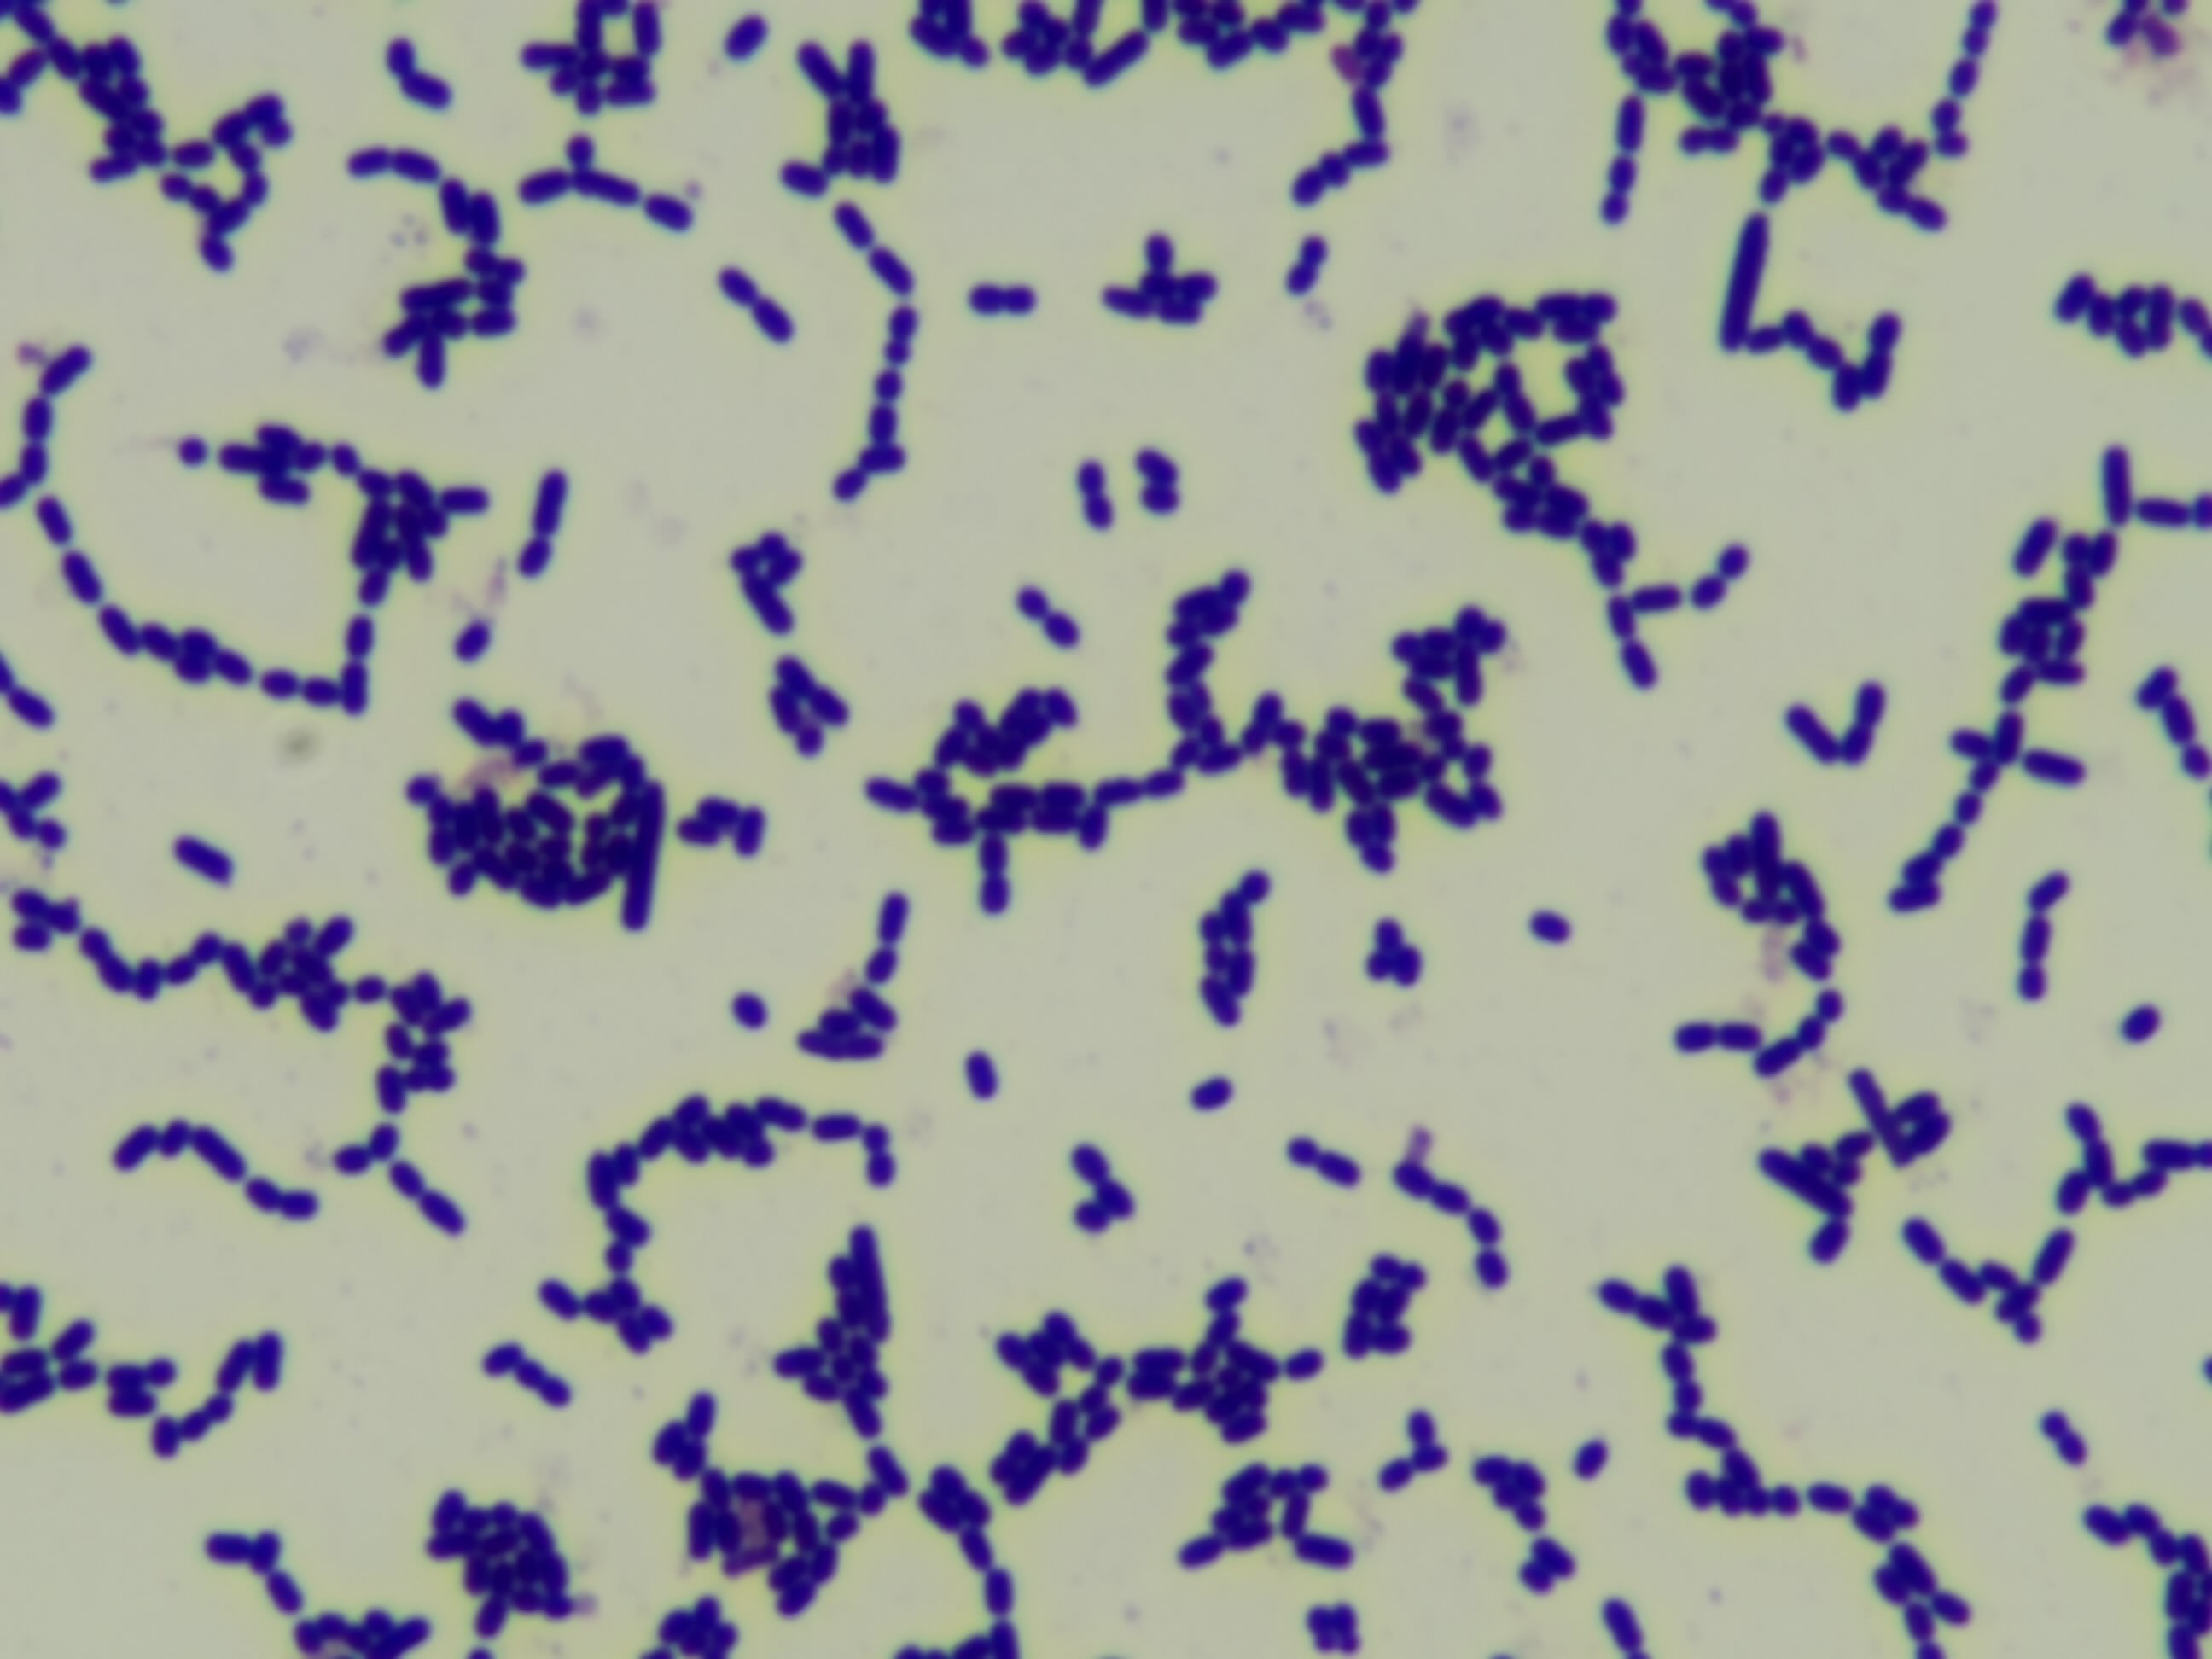

Lactobacillus plantarum
Product description
Lactobacillus plantarum, now classified as Lactiplantibacillus plantarum, is a versatile and widely studied Gram-positive lactic acid bacterium. This species is prevalent in various fermented foods and the gastrointestinal tract of humans and animals.
Read more
Specifications
Products from other suppliers
❮
❯
-

Sea Cucumber & Oyster Tablet
-

Bifidobacterium longum BORI
-

Pep2Dia®, new bioactive ingredient that regulates blood sugar levels after meals.
-

CRISPYTEC Series
-

GLP-1 Probiotics - Akkermansia muciniphila AH39 & Lactobacillus casei CCFM419
-

BiPRO® 9500 whey protein isolate (WPI)
-

Crispact® Stick packs
-

Nextida® GC
-

Gasbet tablets
-

NEUROMAX®
Lactobacillus plantarum